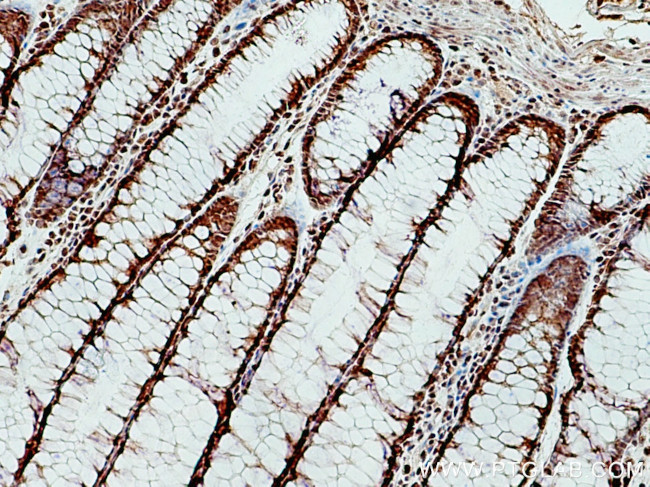
OGT Antibody in Immunohistochemistry (Paraffin) (IHC (P))

Search
Proteintech
OGT Polyclonal Antibody
{{$productOrderCtrl.translations['antibody.pdp.commerceCard.promotion.promotions']}}
{{$productOrderCtrl.translations['antibody.pdp.commerceCard.promotion.viewpromo']}}
{{$productOrderCtrl.translations['antibody.pdp.commerceCard.promotion.promocode']}}: {{promo.promoCode}} {{promo.promoTitle}} {{promo.promoDescription}}. {{$productOrderCtrl.translations['antibody.pdp.commerceCard.promotion.learnmore']}}
产品信息
11576-2-AP
种属反应
已发表种属
宿主/亚型
分类
类型
抗原
偶联物
形式
浓度
规格
纯化类型
保存液
内含物
保存条件
运输条件
产品详细信息
Immunogen sequence: MASSVGNVA DSTGLAELAH REYQAGDFEA AERHCMQLWR QEPDNTGVLL LLSSIHFQCR RLDRSAHFST LAIKQNPLLA EAYSNLGNVY KERGQLQEAI EHYRHALRLK PDFIDGYINL AAALVAAGDM EGAVQAYVSA LQYNPDLYCV RSDLGNLLKA LGRLEEAKAC YLKAIETQPN FAVAWSNLGC VFNAQGEIWL AIHHFEKAVT LDPNFLDAYI NLGNVLKEAR IFDRAVAAYL RALSLSPNHA VVHGNLACVY YEQGLIDLAI DTYRRAIELQ PHFPDAYCNL ANALKEKGSV AEAEDCYNTA LRLCPTHADS LNNLANIKRE QGNIEEAVRL YRKALEVFPE FAAAHSNLAS VLQQQGKLQE ALMHYKEAIR ISPTFADAYS NMGNTLKEMQ D (1-400 aa encoded by BC014434)
靶标信息
This gene encodes a glycosyltransferase that catalyzes the addition of a single N-acetylglucosamine in O-glycosidic linkage to serine or threonine residues. Since both phosphorylation and glycosylation compete for similar serine or threonine residues, the two processes may compete for sites, or they may alter the substrate specificity of nearby sites by steric or electrostatic effects. The protein contains multiple tetratricopeptide repeats that are required for optimal recognition of substrates. Alternatively spliced transcript variants encoding distinct isoforms have been found for this gene.
仅用于科研。不用于诊断过程。未经明确授权不得转售。
生物信息学
蛋白别名: FLJ23071; MGC22921; O linked N-acetylglucosamine transferase; o-glcnac transferase; O-GlcNAc transferase p110 subunit; O-GlcNAc transferase subunit p110; O-linked N-acetylglucosamine (GlcNAc) transferase (UDP-N-acetylglucosamine:polypeptide-N-acetylglucosaminyl transferase); O-linked N-acetylglucosamine transferase 110 kDa subunit; OGT; UDP-N-acetylglucosamine--peptide N-acetylglucosaminyltransferase 110 kDa subunit; UDP-N-acetylglucosamine:polypeptide-N-acetylglucosaminyl transferase; unnamed protein product; uridinediphospho-N-acetylglucosamine:polypeptide beta-N-acetylglucosaminyl transferase
基因别名: 1110038P24Rik; 4831420N21Rik; AI115525; HINCUT-1; HRNT1; MRX106; O-GLCNAC; OGT; OGT1; Ogtl; XLID106
UniProt ID: (Human) O15294, (Mouse) Q8CGY8, (Rat) P56558
Entrez Gene ID: (Human) 8473, (Mouse) 108155, (Rat) 26295